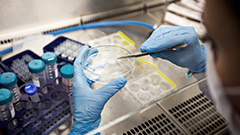

發展歷程
激情投入,堅韌不拔,持續創新,合作共贏

激情投入,堅韌不拔,持續創新,合作共贏

公司成立
被認定為高新技術企業
“大清生物紙”取得中國食品藥品檢定研究院注檢報告
獲得國家醫療器械生產企業許可證
公司產品“大清生物紙”進入臨床
公司產品“大清生物紙”臨床出組
取得“大清生物紙” 醫療器械注冊證【國食藥監械(準)字2006第3640272號】
北京德得創業科技有限公司正式收購北京大清生物技術有限公司

在中關村昌平科技園區建成高科技生產基地GMP廠房并投產
通過醫療器械質量管理體系認證(ISO 9001:2008,ISO13485:2003)
可吸收止血膜(大清生物紙)取得SFDA醫療器械注冊證
獲得國家口腔科材料醫療器械經營許可證
國家高新技術企業通過再認證
成為中關村高新技術企業
被認定為海淀區創新企業
可吸收止血膜(商品名:大清生物紙)被認定為北京市自主創新產品
通過ISO13485認證年檢
拜歐金通過國家SFDA技術審評
舉辦首屆全國代理商大會

同種異體骨修復材料(拜歐金)取得SFDA醫療器械注冊證
通過醫療器械質量管理體系再認證(ISO 9001:2008,ISO13485:2003)
國家高新技術企業通過再認證
舉辦第二屆全國代理商大會
舉辦同種異體骨修復材料-拜歐金產品上市會
牙齒脫敏劑(奧敏清)取得SFDA醫療器械注冊證
中關村高成長企業TOP100
入選中關村科技園區“瞪羚企業”
收購重慶宗申軍輝生物技術有限公司及重慶宗申醫達生物技術研發有限公司
公司參與浙江大學、301醫院承擔國家863項目子課題研究
首屆中國創新創業大賽中取得北京賽區第一名,全國決賽第二名的好成績
第三屆全國代理商大會
中關村高成長企業TOP100
北京生物醫藥產業跨越發展工程(G20工程)企業
最具成長性企業獎
同種異體骨修復材料獲得中關村國家自主創新示范區新技術新產品(服務)證書

中關村高成長企業TOP100
中關村科技園區海淀園管理委員海帆企業
排名2014福布斯中國非上市潛力企業TOP15
北京市國際科技合作基地
國家火炬計劃重點高新技術企業
可吸收止血膜獲得國家重點新產品
北京市專利試點單位
第四屆全國代理商大會
牽頭301醫院、第三軍醫大學承擔科技部863課題攻關
中關村高成長企業TOP100
北京市誠信創建企業
同種異體骨獲得北京市新技術新產品(服務)證書
大清生物紙獲得北京市新技術新產品(服務)證書
“同種異體骨修復材料”獲科技部“火炬計劃”產業化示范項目
中關村高成長企業TOP100成就獎
收購北京西格東方電子醫療技術有限公司、天津中津生物發展有限公司
第五屆全國經銷商大會
北京市企業技術中心
SIS生物疝修補片“瑞拜善”成功舉辦新品上市會
舉辦第六屆全國經銷商大會
牽頭六家科研院所承擔國家十三五重點研發計劃

可吸收止血膜獲CE認證
雙組份止血膜獲注冊證
大清生物研發中心被認定為北京市級企業科技研究開發機構
科健生物取得生產許可證,重慶大清取得骨捷注冊證、生產許可證、經營許可證
天津大清搬入新廠房
北京市研發機構
